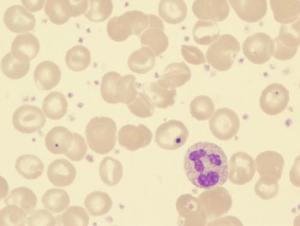
血小板疾病

常見類型
血小板減少症
血小板計數持續低於 100×109/升(L),很常見,一般認為血小板在50×109/L時易伴自發出血,在20×109/L時常有較明顯自發出血。引起血小板減少的原因很多,按其發生機理有:生成減少,某些藥物和病毒感染只選擇性抑制骨髓巨核細胞而誘發血小板減少,另外放射、化療、腫瘤或葉酸和維生素B12缺乏等在引起全血細胞生成減少的情況下使血小板減少;破壞過多,包括藥物免疫性和某些自身免疫病、特發性血小板減少性紫癜及由於瀰漫性血管內凝血和血栓性血小板減少性紫癜等引起的血小板消耗過多;分布異常,常由於巨大脾臟扣押引起。
血小板增多症
血小板計數持續高於600×109/L,可原發於骨髓增殖性疾病,特別是原發性血小板增多症,也可繼發於嚴重出血和溶血、惡性腫瘤(如肺癌)、感染(如結核)、藥物反應(如腎上腺素)、脾切除術後。
血小板功能缺陷病
一組因血小板粘附、聚集、釋放和促凝等功能缺陷引起的出血性疾病,包括兩大類:一是遺傳性功能缺陷病,如血小板粘附異常(巨大血小板綜合徵、血管性假血友病)、血小板聚集異常(血小板無力症、無纖維蛋白原血症)、血小板分泌異常(貯存池病等)、血小板第3因子異常(血小板病);二是獲得性血小板功能缺陷病,很常見,常繼發於骨髓增殖性疾病、尿毒症、異常蛋白血症(多發性骨髓瘤等)、藥物(阿斯匹林、潘生丁)及其他疾病(如肝硬變、白血病、免疫性血小板減少性紫癜)。治療主要針對病因,積極治療原發病,有明顯出血者,可進行血小板成分輸注。
特發性血小板減少性紫癜
特發性血小板減少性紫癜(idiopathic thrombocytopenic purpura ITP)是以出血及外周血血小板減少,骨髓巨核細胞數正常或增多並伴有成熟障礙為主要表現的常見出血性疾病。日前已公認本病是一種由於患者體內產生自身抗血小板抗體,致使血小板壽命縮短、破壞過多、數量減少為病理特徵的自身免疫性疾病。ITP分急性和慢性兩種,在疾病早期很難 鑑別,兩者病因病機及轉歸迥然不同。兒童80%為急性AITP),無性別差異,春冬兩季易發病,多數有病毒感染史,為自限性疾病。一般認為是急性病毒感染後的一種天然免疫反應,一但病源清除,疾病在6-12個月痊癒。而成人們ITP95%以上為慢性(CITP),男女之比約1:3,一般認為屬自身免疫性疾病的一種。本病病死率為1%,多數是因顱內出血而死亡。
繼發性血小板減少性紫癜
其臨床表現除有皮膚、黏膜等出血症狀及化驗檢查血小板減少外,尚有原發病的特徵。中醫學屬於血證發斑、斑疹等範疇。
發病原因
血小板疾病
血小板疾病1. 引起骨髓再生低下低下或障礙伴全血細胞減少的藥物。 在一定劑量下易引起骨髓再一低下的化學物質及藥物:
①苯、二甲苯等。②烷化劑:如氮芥、環磷醯胺、苯丙酸氮芥等。③抗代謝藥:如阿糖胞苷、巰基嘌呤等。④抗癌抗生素類:如正定黴素、阿黴素等。⑤其他:如有機砷等。 2. 可以引起骨髓再生障礙或低下的藥物:如氯黴素、磺胺類藥物、青黴素、鏈黴素、新青I號、三甲雙酮、苯妥英鈉、乙琥胺、抗甲狀腺藥(如他巴唑、丙基硫氧嘧啶、甲亢平)、糖尿病藥(如甲磺丁脲、氯磺丁脲、氯磺丙脲等)、保泰松、消炎痛、安定及鎮靜藥(安寧、利眠寧、氯丙嗪等)、金製劑、染髮劉、撲敏寧、撲爾敏、乙醯唑胺等。
3 .選擇性抑制巨核細胞製造血小板的藥物:如氯噻嗪類藥、雌激素類、乙醇、甲磺丁脲、瑞斯脫黴素等。
血小板疾病的日常護理
生活調理
①預防感冒,密切觀察紫斑的變化。
②發病較急,出血嚴重者需絕對臥床。緩解期應注意休息,避 免過勞,避免外傷。
③慢性患者,可根據體力情況,適當進行鍛鍊。
④若有藥物過敏,在用藥時應該避免。
⑤注意皮膚清潔,避免過度抓撓,以防抓破感染。紫斑若有皮 膚瘙癢者,可用爐甘石洗劑或九華粉洗劑塗擦。
飲食調理
1.飲食宜軟而細。如有消化道出血,應給予半流質或流質飲食,宜涼不宜熱, 忌食菸酒辛辣之物。
2.可給蔬菜水果、綠豆湯、蓮子粥,忌用發物如魚、蝦、蟹、腥味之食物。
3.忌食山楂。
精神調理
調節情緒,避免情緒波動或精神刺激。
血小板減少性紫癜患者日常注意事項
1.緩解階段可以適當參 加一些鍛鍊,如散步、慢跑、打太極拳等,以增強體質,提高抗病能力。
2.飲食要有規律,主副食應以高蛋白高維生素為主,如小麥、 玉米、小米、糯米、豆類、瘦肉、蛋類等。多吃新鮮水果,如橘子、紅棗、核桃、紅皮花生、菠菜、青椒 、覓菜、白菜等。忌辛辣、油膩及不易消化的食物,菸酒等刺激類物品應以戒除。
3.儘可能避免使用能引起血小板減少的藥物,如利福平、阿司 匹林、奎寧、頭孢菌素、洋地黃毒甙等。
4.平時宜保持心情舒暢,避免精神過度緊張。要保持個人衛生 ,預防各種感染,特別要注意防止外傷的發生。
護理措施
1.密切觀察病情,及時發現出血所致的危急情況 ①觀察皮膚 瘀點(斑)變化。②觀察血小板數量變化。當外周血小板<20×109/L時,常有自發性出血。血小板數量 愈少出血現象愈重,故對血小板數量極低者需密切觀察有無出血情況發生。③嚴重出血時,如鼻衄、內臟 出血、顱內出血,需定時測血壓、脈搏、呼吸,觀察面色,記錄失血量。如面色蒼白加重,呼吸脈搏增快 ,出汗、血壓下降提示失血性休克。若有煩躁不安、嗜睡、頭痛、嘔吐、甚至驚厥,提示顱內出血。顱內 出血時出現呼吸變慢不規則、雙側瞳孔大小不等,提示合併腦疝。顱內出血常危及生命。消化道出血時常 有腹痛、便血。血尿、腰痛,提示腎出血。
2.止血 鼻、口黏膜出血可用浸有1%麻黃素或0.1%腎上腺素 的紗條、棉球或明膠海綿壓迫局部。如上述壓迫止血無效,立即採用其它止血措施。對嚴重出血者需,輸 注同血型血小板。
3.消除恐懼心理 患者對出血及止血技術操作可能產生懼怕, 表現哭鬧、躁動、不合作使出血加重。故術前需講明道理,儘量消除恐懼心理,爭取患者配合。
4.避免損傷 ①床頭床欄用軟塑膠製品包紮,限制劇烈活動、 以免碰傷、刺傷、摔傷引起出血。②儘量減少肌內注射,以免引起深部血腫。③禁食堅硬和多刺的食物。 ④保持大便通暢,以免排便致腹壓增高誘發顱內出血。
5.預防感染 患者病室應與感染病室分開。注意保持出血部位 清潔。
6.健康教育 ①指導壓迫止血方法。②指導自我保護方法。如 服藥期間不與感染患者接觸,去公共場所需戴口罩,衣著適度,儘可能避免感染,以免引起病情加重或復 發。③指導預防外傷方法。如不使用硬質牙刷、不挖鼻孔、不玩銳利的玩具和工具,不做易發生外傷的運 動。④溶血性貧血預後多數良好。但少數可轉為慢性或復髮型。故應指導家長識別出血徵象,如瘀點、黑便,一 旦發現出血立即回院複查及治療。⑤脾切除治療的患者易患呼吸道及皮膚化膿性感染,甚至敗血症。在術 後2年內,患者應定期隨診,每月口服青黴素數日或肌內注射長效青黴素1次,酌情注射丙種球蛋白,以增 強抗感染能力。

